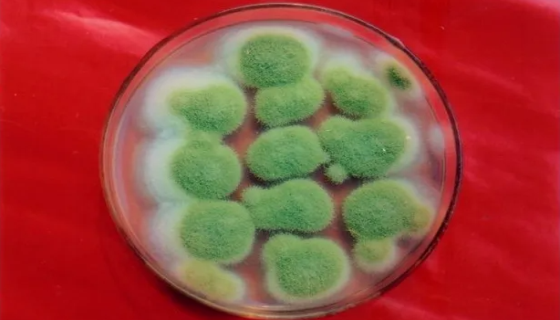
米曲霉的形态特征与生理特性及主要应用！
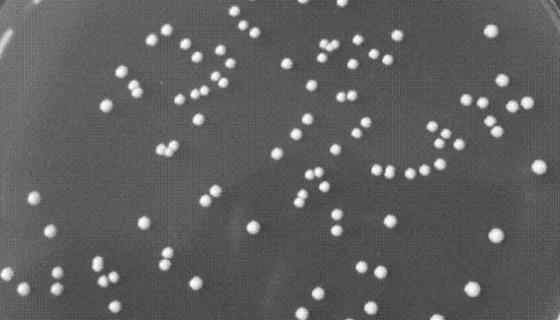
乳酸乳球菌乳酸亚种双乙酰变种打管说明书！

NCI-H1437人肺癌细胞的处理方法与培养步骤!
NCI-H1437人肺癌细胞收到后的处理方法与培养步骤及注意...
米曲霉的形态特征与生理特性及主要应用!
米曲霉(Aspergillus oryzae)属于黄曲霉群,...

小鼠髓样树突状细胞复苏与传代及冻存操作说明!
小鼠髓样树突状细胞的复苏与传代及冻存操作说明!

结核分枝杆菌的生物学特性与实验室检查!
结核分枝杆菌(Mycobacterium tuberculo...

栖瘤胃普雷沃氏菌 百欧博伟生物 ATCC 19189
ATCC 19189 栖瘤胃普雷沃氏菌知识解析。

无色杆菌属的培养条件与注意事项及保藏方法!
无色杆菌属是Achromobacter属的微生物,原产地为中...

ATCC 700842 百欧博伟生物 微生物菌种
ATCC 700842知识简介,是百欧博伟生物的ATCC菌种...

人膀胱癌细胞接收后的处理方法与培养步骤!
人膀胱癌细胞的处理方法与培养步骤及需要注意的事项有哪些?
乳酸乳球菌乳酸亚种双乙酰变种打管说明书!
乳酸乳球菌乳酸亚种双乙酰变种是Lactococcus属的微生...